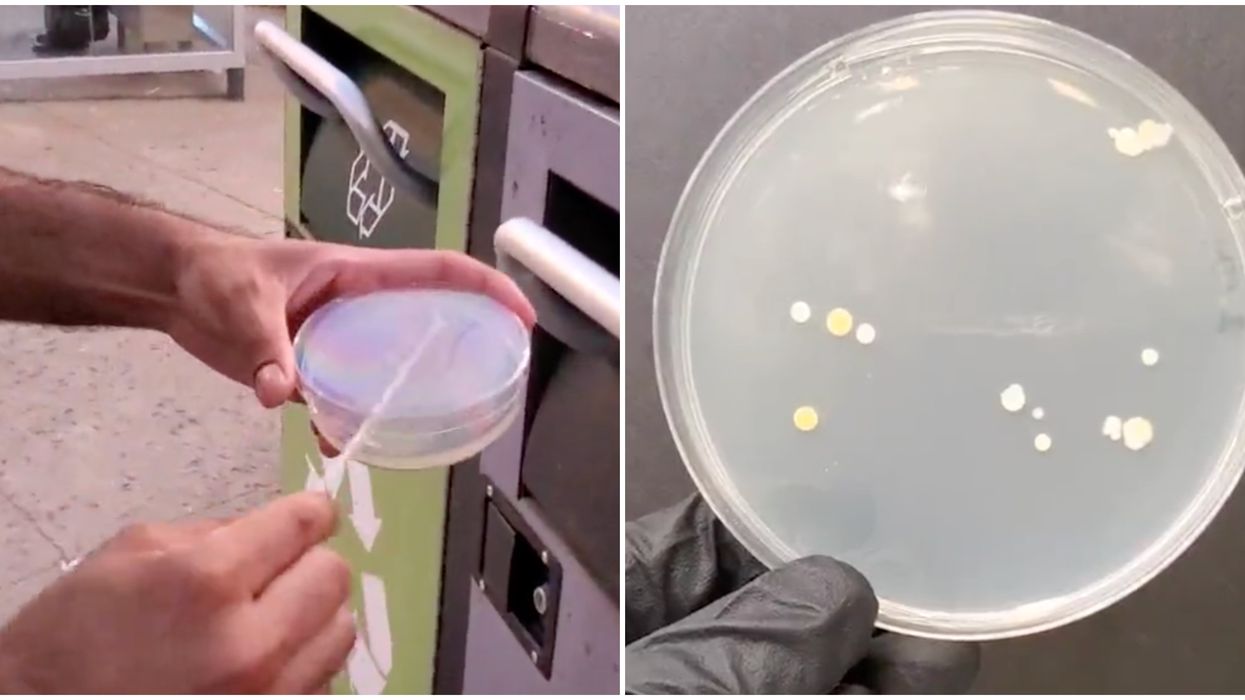
A Scientist Tested Montreal Spots For Bacteria & Revealed How Dirty They Are On TikTok

A Scientist Tested Montreal Spots For Bacteria & Revealed How Dirty They Are On TikTok
With a virus ruling our lives at the moment, many of us are thinking about germs: Where are they? How do we avoid them? What spots in Montreal are dirtier than others?
Dilhan Perera, a PhD candidate in experimental medicine at McGill University and local TikToker with 670,400 followers, decided to investigate by conducting an actual experiment and posting the results to TikTok.
Editor's Choice: A Montreal Company Used The Bloc's 'Bonjour-HO!' As Inspo For Its New 'Bonjour Hoe' Shirts
“
Let's see how dirty the city is. I ran around Montreal and collected samples from commonly touched locations to see how much bacteria I could isolate.
Dilhan Perera on TikTok
Perera is a teaching assistant in microbiology and parasitology so he knows a thing or two about bacteria.
In part one of a video titled, "How dirty is Montreal?" Perera is seen swabbing the handle of a public garbage can, a convenience store ATM machine, an STM ticket machine, a metro pole grip inside one of the cars, metro station exit doors, and a gas pump.
Perera says he then brought the "plates" — also known as Agar plates or petri dishes — back to the lab and put them in an incubator at 37 degrees celsius to grow overnight.
@ta.dil IS MONTREAL ✨dirty✨ ??? #learnontiktok #microbiology #lab
Part two reveals his results after 24 hours. This is what he found:
- Garbage Can: 11 colonies of growth, which all look the same
- ATM: 23 colonies, some of which were yellow
- STM Ticket Machine: 70+ colonies of growth
- Metro Pole Grip: 2 colonies
- Metro Door: 7 colonies
- Gas Pump: 7 colonies but one is oddly shaped and massive
So, aside from being wary of STM ticket machines, what does this mean?
Perera told MTL Blog that since this was a superficial qualitative experiment, all he could tell was whether or not bacteria was present.
Different shapes and colours indicate different types of bacteria, but he said he could not tell which types, as he did not test for that.
It is very possible that these are harmless common skin bacteria, Perera said, "but some could be opportunistic pathogens and cause infection if they get into a cut [or] wound."
@ta.dil SHOULD I MAKE MORE OF THESE?? #microbiology #learnontiktok #science
"I think the biggest thing to take away from this is that bacteria are everywhere and alive, and they can be spread by touching commonly touched locations, so just drawing attention to the importance of keeping our hands well washed and clean," Perera said.
Perera hasn't conducted a similar experiment in any other city, but he said he expects the results would be similar.
"I was actually expecting more growth! I think that COVID-19 could have affected my results because things — especially in the metro — are supposedly more often cleaned, and our hygiene habits are moving towards constantly sanitizing our hands."
For more Montreal science experiments, follow @ta.dil on TikTok.